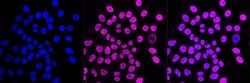
Invitrogen FDPS Recombinant Rabbit Monoclonal Antibody (23GB1395), Invitrogen

missing translation for 'onlineSavingsMsg'
Läs mer
Läs mer
Invitrogen™ FDPS Recombinant Rabbit Monoclonal Antibody (23GB1395), Invitrogen™


Beskrivning
The isoprene biosynthetic pathway supply the cell with cholesterol, ubiquinone, and various nonsterol metabolites. The farnesylpyrophosphate synthetase enzyme catalyzes the formation of geranyl and farnesylpyrophosphate from isopentenylpyrophosphate and dimethylallyl pyrophosphate. Analysis of FDPS activity and protein in rat liver, accompanied by immunofluorescence and immunoelectron microscopy studies, demonstrated that FDPS is predominantly localized in peroxisomes. 1 Liver tissue from patients with the peroxisomal deficiency diseases Zellweger syndrome and neonatal adrenoleukodystrophy exhibit diminished activities of FDPS and subsequent isoprenoid synthesis.

Specifikationer
Specifikationer
| Antigen | FDPS |
| Användningsområden | Flow Cytometry, Western Blot, Immunocytochemistry |
| Klassificering | Recombinant Monoclonal |
| Klona | 23GB1395 |
| Koncentration | 0.6 mg/mL |
| Konjugera | Unconjugated |
| Formulering | PBS with 50% glycerol and 0.02% sodium azide; pH 7.4 |
| Gen | FDPS |
| Genaccessionsnr. | P14324 |
| Gene Alias | (2E,6E)-farnesyl diphosphate synthase; 6030492I17Rik; Ac2-125; AI256750; cholesterol-regulated 39 kDa protein; CR 39; dimethylallyltranstransferase; Farnesyl diphosphate synthase; farnesyl diphosphate synthase (farnesyl pyrophosphate synthetase, dimethylallyltranstransferase, geranyltranstransferase); farnesyl diphosphate synthetase; farnesyl pyrophosphate synthase; farnesyl pyrophosphate synthetase; farnesyl pyrophosphate synthetase, dimethylallyltranstransferase, geranyltranstransferase; Fdps; Fdpsl1; FPP synthase; FPP synthetase; FPPS; FPS; geranyltranstransferase; KIAA1293; mKIAA1293; POROK9; testis-specific farnesyl pyrophosphate synthetase |
| Visa mer |
Produkttitel
Genom att klicka på Skicka bekräftar du att du kan bli kontaktad av Fisher Scientific angående feedbacken du har lämnat i detta formulär. Vi kommer inte att dela din information för andra ändamål. All kontaktinformation som tillhandahålls ska också underhållas i enlighet med vår Sekretesspolicy.
Hittar du en möjlighet till förbättring?